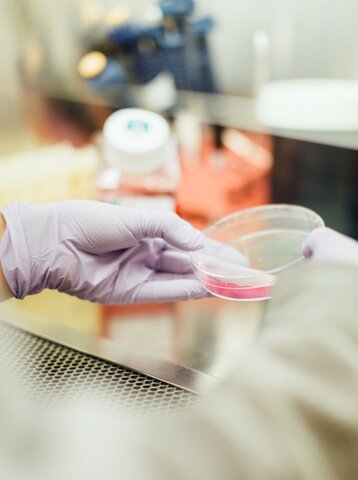
Atividades Complementares

-
 A Matriz curricular do curso de Medicina da FASAI conta com metodologias ativas de ensino inovadoras, lançando mão de estratégias com pequenos grupos de aprendizagem.
A Matriz curricular do curso de Medicina da FASAI conta com metodologias ativas de ensino inovadoras, lançando mão de estratégias com pequenos grupos de aprendizagem.
Exemplo: Aprendizagem em Pequenos Grupos (APG), Método de Aprendizagem por Raciocínio Clínico (MARC) e Raciocínio Clínico Cirúrgico (RCC). -
 Relatório e Recomendações.
Relatório e Recomendações. -
 Na operacionalização da matriz curricular o sistema avaliativo preconiza avaliações de cunho diagnóstico, somativo e formativo, com foco no desenvolvimento de competências para formação médica atualizada. O percurso avaliativo foi pensado e validado pelo NDE.
Na operacionalização da matriz curricular o sistema avaliativo preconiza avaliações de cunho diagnóstico, somativo e formativo, com foco no desenvolvimento de competências para formação médica atualizada. O percurso avaliativo foi pensado e validado pelo NDE.
Exemplo: Teste de Progresso Institucional. -
Consolidação das atividades complementares, reforçando a importância das ações de extensão, ensino, inovação, internacionalização e profissionalização.
Consolidação das atividades complementares, reforçando a importância das ações de extensão, ensino, inovação, internacionalização e profissionalização. -
 OMS declara COVID-19 como pandemia.
OMS declara COVID-19 como pandemia.
18/03/2011: Suspensão de aulas presenciais e planejamento das atividades remotas de aprendizagem. -
 Através de decisão colegiada, analisada e aprovada pelo NDE e Colegiado, foi instituído o REAR. Esse regime de aprendizagem surge para realização das atividades teóricas de forma síncrona no período de pandemia.
Através de decisão colegiada, analisada e aprovada pelo NDE e Colegiado, foi instituído o REAR. Esse regime de aprendizagem surge para realização das atividades teóricas de forma síncrona no período de pandemia.
Observação: Contratação de plataformas digitais para ensino-aprendizagem (Zoom Meeting, Plataforma CANVAS, Paciente 360º, Lt ADInstruments, Medical Harbour). -
 Retorno às atividades práticas presenciais após decretos e diminuição de mortes por COVID-19, seguindo protocolos de biossegurança.
Retorno às atividades práticas presenciais após decretos e diminuição de mortes por COVID-19, seguindo protocolos de biossegurança. -
 Retorno às atividades teóricas presenciais, seguindo os protocolos de biossegurança.
Retorno às atividades teóricas presenciais, seguindo os protocolos de biossegurança. -
 Estruturação da equipe de Internato e manual.
Estruturação da equipe de Internato e manual.
Estabelecimento de convênios, contratação e capacitação de docentes/preceptores dos serviços conveniados.
Uso de plataformas digitais (Whitebook e UpToDate). -
 Discussões para o aprendizado pós-COVID.
Discussões para o aprendizado pós-COVID. -
 Discussões no NDE sobre a curricularização da extensão na matriz curricular para 2023.
Discussões no NDE sobre a curricularização da extensão na matriz curricular para 2023. -
 Implantação da Curricularização da Extensão.
Implantação da Curricularização da Extensão.
Uso de tecnologias inovadoras.
Teste Adaptativo Computadorizado (CAT).
Certificação do Centro de Simulação em Saúde.
A list shows items. A timeline shows sequence.
Use Timetoast to make dates, milestones, and turning points easier to understand in a clear visual format. Timetoast is a timeline maker for work, school, research, and stories.